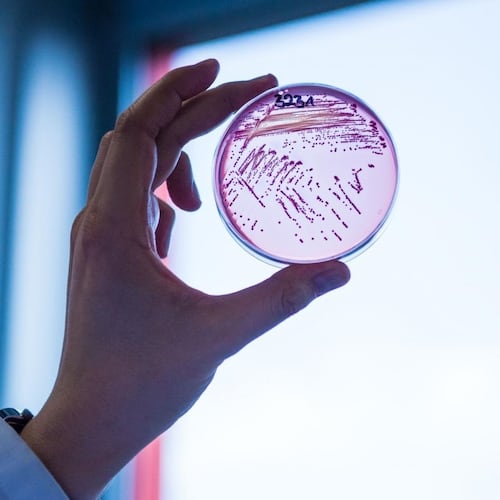

Los hospitales y centros sanitarios son entornos donde la calidad del aire es crucial para la salud de pacientes y personal. La presencia de patógenos respiratorios puede comprometer la seguridad y bienestar de todos. A continuación, se detallan los cinco virus y bacterias más comunes en infecciones respiratorias adquiridas en entornos hospitalarios, sus implicaciones y cómo la solución BIODUCT puede mitigar estos riesgos.
1. Virus Respiratorio Sincitial (VRS)
- Problemas que puede generar: El VRS es una causa principal de bronquiolitis y neumonía en niños pequeños y puede afectar a adultos mayores y personas inmunocomprometidas, provocando infecciones respiratorias graves. merckmanuals.com
2. Rinovirus
- Problemas que puede generar: Principal causante del resfriado común, el rinovirus puede complicar condiciones preexistentes y aumentar el riesgo de infecciones secundarias. merckmanuals.com
3. Adenovirus
- Problemas que puede generar: Causa de infecciones respiratorias agudas, especialmente en niños, y puede llevar a complicaciones como neumonía y bronquitis. merckmanuals.com
4. Mycoplasma pneumoniae
- Problemas que puede generar: Bacteria responsable de la neumonía atípica, conocida por su presentación clínica insidiosa y potencial para brotes nosocomiales. scielo.sa.cr
5. Klebsiella pneumoniae
- Problemas que puede generar: Bacteria que puede causar infecciones respiratorias graves, especialmente en personas con sistemas inmunes debilitados. elpais.com
Solución BIODUCT: Mitigando Riesgos en Sistemas de Ventilación
La solución BIODUCT, un conducto de ventilación de chapa galvanizada con revestimiento interno de pintura biocida, fungicida y bactericida, ofrece una barrera efectiva contra estos patógenos. Su eficacia superior al 99% en inhibición de microorganismos se ha demostrado en estudios certificados por laboratorios como LEITAT y el Instituto Valenciano de Microbiología (IVAMI).
Además, la versión BIODUCT ULTRAVIOLET incorpora luces UV-C esterilizantes, proporcionando una desinfección adicional del aire en circulación. Esta combinación de tecnologías asegura un ambiente más seguro y saludable en hospitales y centros sanitarios.
Implementar sistemas de ventilación como BIODUCT no solo mejora la calidad del aire, sino que también reduce el riesgo de infecciones respiratorias nosocomiales, protegiendo a pacientes y personal sanitario.
Últimas noticias sobre infecciones respiratorias y medidas preventivas
elpais.com
Las superbacterias causan en España ocho veces más muertes de las que se estimaban, enlace
elpais.com
Un brote letal de la bacteria ‘Klebsiella oxytoca’, la última batalla en los hospitales mexicanos, enlace

cadenaser.com
¿Sabías que hay ciencia detrás de ventilar las habitaciones? enlace